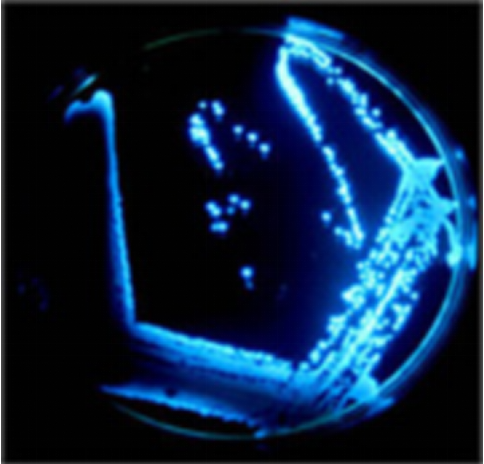

生物发光是很常见的现象,夏日夜晚萤火虫的飞舞和海边夜光藻聚集造成的“蓝眼泪”是无数人打卡拍照的独特景象。发光的物体,看起来是挺好看的,要是送入口中做食物的话,你是不是就得怀疑一下安全问题了。网上就曾流传过夜光寿司的图片,在强光下看似正常的寿司却在黑暗环境下发出幽幽蓝光。

发光寿司
(图片来源: Facebook截图)
2020年7月,泰国媒体报导了有关夜光寿司的新闻:一位泰国小伙儿买到了这盒寿司,在走出超市的过程中,随着光线逐渐变暗,寿司上虾身上的蓝光时隐时现,直至在完全暗光下发出明亮的蓝光。他将这一奇特现象记录下来,拍成视频上传到社交网络后,引发了大范围的讨论。
这只已经被做成食物的虾为何会发出幽冷的蓝光呢?这种发出荧光的食物还能食用吗?要解决这些问题,我们需要从自然界中的荧光现象开始谈起。
能让猪发光的荧光蛋白
荧光蛋白是非常常见的能导致生物体发光的因素,在受到特定波长光激发后,会发出相应颜色的光。最早被发现的荧光蛋白,是于1962年在维多利亚多管发光水母(Aequorea victoria)中发现的野生型绿色荧光蛋白(Green fluorescent protein,简称GFP)。

维多利亚多管发光水母
(图片来源:wikipedia)
该种水母发光原理比较复杂,首先水母体内的水母素(Aequorin)与腔肠素(Coelenterazine)共价结合产生具备发光能力的稳定中间体,形成的共价键为过氧化键。在钙离子的影响下,共价键断裂,发生氧化反应的同时释放蓝光。这些蓝光可以激活水母体内的荧光蛋白。
之后GFP的发光基团在蓝光的照射下被激活,并以能量的形式发出绿色荧光,这让维多利亚多管水母看起来显得偏绿。
简言之,其自然发光过程需要先产生蓝光来激发GFP,GFP受到激发并发出绿光。

绿色荧光蛋白发光原理
(图片来源:参考文献1 作者汉化)
基于以上现象,现代生物学利用 DNA重组技术将荧光蛋白基因克隆到合适的细胞进行表达,然后借助荧光显微镜即可对被标记的蛋白质进行细胞内活体观察。荧光显微镜会人工模拟上述发蓝光的过程,这样在使用荧光显微镜的时候,便会看到绿色荧光了。
随着对GFP基因的改造,增强型GFP及更多颜色的荧光蛋白被制造出来,人们能够更加简单清晰明了地追踪细胞活动,因此荧光蛋白也被誉为“照亮了生物学研究的未来”。
我国科学家在十多年前已经培育出“夜光猪”,这种克隆猪在特定波长的激发光下可分别发出红、黄、绿、青4种荧光。

中国科学院广州生物医药与健康研究院培育的转基因克隆猪
(图片来源:cas.cn)
那么,新闻中泰国小伙手中的寿司虾之所以发出幽幽的光,是因为体内也有荧光蛋白吗?很可惜并不是这样的。荧光蛋白多发现于刺胞动物中,目前也并没有在常见食用虾中发现荧光蛋白的报导,因此我们基本可以排除荧光蛋白的可能性。
“荧光素-荧光素酶“发光系统下的浮游生物
进入夏季,我国多地海岸均出现“蓝眼泪”现象,波动的海面上泛起点点蓝光,就像是大海流下的蓝色眼泪。这样的景象是由爆发的夜光藻发光形成的。而夜光藻发光的原因正是基于“荧光素-荧光素酶”发光酶促反应。

2022-03-13晚间作者于山东日照海岸拍摄的蓝眼泪
“蓝眼泪”的颜色,是不是就和我们一开始看到的夜光寿司的颜色比较相似了!至于为什么它们都呈现蓝色,大概是由于光在水中的传播与大气中有很大的不同,蓝光和绿光在海水中具有最强的穿透性,因此大多数海洋发光生物都发蓝光或者绿光。这也造成了一个有趣的现象,在无光的深海,除了黑色之外,红色同样具有优秀的隐身效果,这也可以解释为什么很多深海生物有着红色的外表。

光在水中的传播
(图片来源:wikipedia)
在发光浮游生物中,荧光素在荧光素酶的催化下发生氧化反应,生成激发态荧光素并发光。发光甲藻、水母、栉水母、海萤和火萤等多种海洋生物都因此发光。陆生的萤火虫也是基于此种原理发光。值得注意的是,不同物种使用的荧光素和荧光素酶并不相同,其反应过程也存在差异。

不同物种素酶反应的过程 A萤火虫 B 白线蚓 C 海萤 D 发光淡水帽贝 E 发光细菌 F 磷虾
(图片来源:参考文献3)
不同于荧光蛋白的被动发光,荧光素酶反应属于生物的真发光。也正因为如此,这种发光系统有时需要外部扰动或者神经控制来激发。而且具有一定的昼夜周期性或者季节周期性。
不过能发光的浮游生物主要附着在虾的头胸甲、附肢和外壳上,在去壳后依然能使肌肉发光的可能性并不高。新闻中的寿司虾已经被剥去了外壳,所以可能也不是这种酶促反应使它发光的。
发光磷虾
有没有一种可能,这只寿司上的小虾,本身就属于会发光的虾类呢?
磷虾科(Euphausiidae)的生物都能发光,磷虾发光具有季节周期性,通常在秋季发光,在受到惊吓时也会发光。

左:磷虾 右:发光的磷虾
(图片来源:wikipedia)
磷虾具有被称作发光器的器官,外观为金黄色略带红色的球形,内有晶体、发光体、反射器和神经。磷虾同样采用“荧光素——荧光素酶”发光系统发光,与发光甲藻不同的是,磷虾自身并不能产生荧光素,它们只能通过摄食发光甲藻的方式从外界获取荧光素来完成酶促反应。

磷虾结构示意图及发光器解剖结构
(图片来源:wikipedia 参考文献2 作者汉化)
磷虾的发光器主要分布于眼柄下方以及步足和腹足的下方,发光部位与夜光寿司呈现的景像并不一致。而且很可惜,磷虾的生理特征并不适合做成寿司,因此发光寿司为磷虾的可能性也不大。
海洋发光细菌
现在还有一种可能,寿司虾是不是被会发光的细菌入侵了?
能进行生物发光的细菌称为发光细菌,它们绝大多数是海生细菌,海洋发光细菌可以共生在鱿鱼和硬骨鱼类的身上,目前已经发现5属20多种。

部分发光细菌及寄主
(图片来源:wikipedia)
在发光细菌中,发光操纵子(Lux operon)控制着发光相关基因的表达,野生的发光基因系统包括结构基因LuxC、D、A、B、E。其中LuxA和B分别编码了细菌荧光素酶的α亚基和 β亚基。LuxC、D和E分别编码依赖NADPH的脂肪酸还原酶、酰基转移酶和ATP合成酶。
所有的发光细菌都具有相似的发光反应机制,在氧气和荧光酶的作用下,将还原型的黄素单核苷酸(FMNH2)及长链脂肪醛氧化为氧化型的黄素单核苷酸(FMN)及长链脂肪酸,并发射出波长490纳米的蓝绿光。细菌荧光素酶反应的最佳温度为18℃,超过25℃即迅速失活。

发光细菌的基因表达及生化原理
(图片来源:参考文献4)
根据上述信息推断,泰国小伙儿买到的寿司发光大概率是因为被发光细菌污染,当地检疫部门也在后续的检测中检查出发光细菌。
从海洋到人们的口中,被污染小虾的发光细菌是如何坚强地存活下来的呢?应该是在捕捞后未彻底清洗留下了菌种,同时寿司采用生肉加米饭的制作工艺和低温储存环境都有利于发光细菌的生存,经过一段时间的繁衍,最终使得这个寿司在暗夜里发出幽冷的蓝光。
无独有偶,曾经也有新闻报导了国外多地出现生猪肉发蓝光的案例,经过当地检疫部门的检测,确认为发光细菌荧光假单胞菌(Pseudomonas fluorescens)所致。
发光中的细菌
(图片来源:wikipedia)
结语
最后,我们仅从海洋生物自然发光的角度,分析了发光寿司存在的原因。针对生活中其他的食材发光现象,并不能排除另外的可能性,如食材处理时混入磷等发光物等。另外需要提醒大家,如果在生活中遇到了发光食品,可以交付给相关部门进行检测,请不要食用。
编辑:郭雅欣
参考文献
[1] Bhuckory, S., Kays, J. C., & Dennis, A. M. (2019). In vivo biosensing using resonance energy transfer. Biosensors, 9(2), 76.
[2] 郑重, 李少菁. 海洋浮游生物发光研究的回顾与展望—海洋浮游生物学新动向之十三[J]. 自然杂志,1987, 6: 31-36.
[3] Yan, Y., Wang, S., Xie, F., Fang, X., Zhang, Y. M., & Zhang, S. X. A. (2019). Firefly-inspired approach to develop new chemiluminescence materials. Iscience, 13, 478-487.
[4] Sun, S., Yang, X., Wang, Y., & Shen, X. (2016). In vivo analysis of protein–protein interactions with bioluminescence resonance energy transfer (BRET): progress and prospects. International journal of molecular sciences, 17(10), 1704.
[5] 崔庆宇, 王明钰, 徐海. 细菌lux荧光报告系统的研究进展[J]. 中国生物工程杂志, 2017, 37(8): 66-71.
(注:文中拉丁文部分应为斜体。)